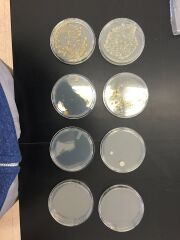

Uploads by Nadine Rotundo
From OpenWetWare
Jump to navigationJump to search
This special page shows all uploaded files.
| Date | Name | Thumbnail | Size | Description |
|---|---|---|---|---|
| 07:44, 12 February 2015 | IMG 3843.JPG (file) |  |
1.47 MB | |
| 07:40, 12 February 2015 | IMG 383111114.JPG (file) |  |
1.42 MB | |
| 07:05, 12 February 2015 | 10252098 10204583346277120 6932870819414995535 n.jpg (file) |  |
52 KB | |
| 07:04, 12 February 2015 | 10950699 10204583346717131 154076383926522631 n.jpg (file) |  |
51 KB | |
| 07:03, 12 February 2015 | NadinePlant5.jpg (file) |  |
45 KB | |
| 07:02, 12 February 2015 | NadinePlant1.jpg (file) |  |
50 KB | 1 |
| 15:29, 5 February 2015 | Table 2.pdf (file) | 39 KB | ||
| 07:35, 5 February 2015 | Table 1.txt (file) | 356 bytes | ||
| 07:29, 5 February 2015 | Serial Diffusion.pdf (file) | 55 KB | ||
| 07:27, 5 February 2015 | Figure2OWW4 zps616a74a4.jpg (file) |  |
66 KB | |
| 07:26, 5 February 2015 | Serial Diffusion.jpg (file) |  |
66 KB | |
| 07:21, 5 February 2015 | 10945526 10153034901758186 2083589905515263624 n.jpg (file) | |
66 KB | |
| 07:04, 5 February 2015 | Screen Shot 2015-02-05 at 1.59.39.pdf (file) | 25 KB | ||
| 07:14, 29 January 2015 | IMG 360711111.jpg (file) |  |
878 KB | |
| 05:17, 28 January 2015 | Transect72194.jpg (file) |  |
341 KB | |
| 05:12, 28 January 2015 | IMG 3573.jpg (file) |  |
341 KB |